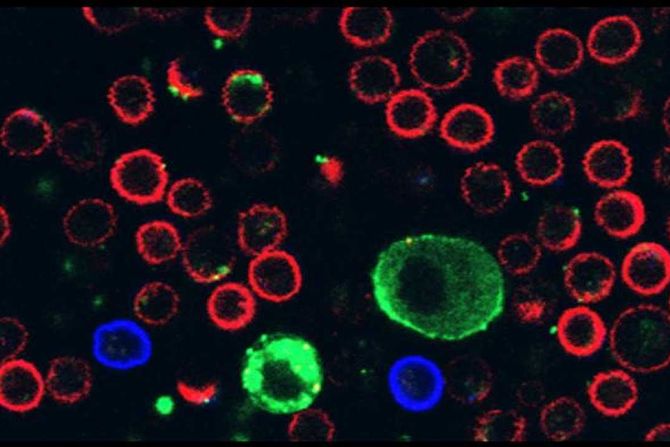
melanom

Otkrivanje mehanizma kojim ćelije melanoma parališu imunske ćelije
Napravljen je veliki korak napred sa dalekosežnim implikacijama po lečenje smrtonosnog raka kože.
Nova međunarodna studija pod vođstvom Fakulteta Grej za medicinske i zdravstvene nauke Univerziteta u Tel Avivu otkriva: ćelije melanoma parališu imunske ćelije lučenjem vanćelijskih vezikula, sićušnih, mehurastih struktura koje luči ćelija. Istraživači veruju da ovo otkriće ima dalekosežne implikacije za moguće tretmane najsmrtonosnijeg oblika raka kože.
Melanom je najsmrtonosniji tip tumora kože. U prvoj fazi bolesti, melanocitne ćelije se nekontrolisano dele u spoljnom sloju kože, epidermisu. U drugoj fazi, ćelije raka prodiru u dermis i metastaziraju putem limfnog i krvnog sistema.
Ranije studije su otkrile da, dok rastu u epidermisu, ćelije melanoma luče velike vanćelijske vezikule poznate kao melanozomi, koji prodiru u krvne sudove i dermalne ćelije, stvarajući povoljno okruženje za širenje ćelija raka. Nova studija je otkrila da ove vezikule takođe omogućavaju ćelijama raka da parališu imunske ćelije koje ih napadaju.
„Na membranama vezikula nalazi se ligand — molekul koji bi trebalo da se veže za receptor prisutan samo na imunskim ćelijama zvanim limfociti; tačnije, na limfocitima koji mogu da ubiju ćelije raka kada dođu u direktan kontakt s njima. Naša hipoteza je bila da ovaj ligand blokira limfocite koji dolaze da ubiju melanom. Došli smo do velikog otkrića: rak u suštini ispaljuje ove vezikule na imunske ćelije koje ga napadaju, remeteći njihovu aktivnost i čak ih ubijajući“, kažu istraživači.
Iako je otkriće izvanredno i može imati dalekosežne terapijske implikacije, potrebno je još mnogo rada kako bi se prevelo u novu terapiju. Omogućiće da se ojačaju imunske ćelije da bi mogle da izdrže protivnapad melanoma.
Istovremeno se mogu blokirati molekuli koji omogućavaju vezikulama da se zakače za imunske ćelije, što bi razotkrilo ćelije raka i učinilo ih ranjivijim. U svakom slučaju, ova studija otvara nova vrata za efikasnu imunoterapijsku intervenciju.
(Telegraf Nauka/EurekAlert)
Video: Intervju sa Edvardom Fergusonom
Nauka Telegraf zadržava sva prava nad sadržajem. Za preuzimanje sadržaja pogledajte uputstva na stranici Uslovi korišćenja.


